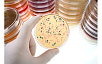

- Биотех
- Каталог
- Расходные материалы для биотехнологических и микробиологических лабораторий
- Чашки Петри
- Чашки Петри одноразовые стерильные
- Круглые чашки Петри асептические, вентилируемые, ⌀ 90мм, высота 14,2мм
Круглые чашки Петри асептические, вентилируемые, ⌀ 90мм, высота 14,2мм
Круглые чашки Петри асептические, вентилируемые, ⌀ 90мм, высота 14,2мм
Описание
Широкий выбор чашек Петри с отличными оптическими характеристиками, способными удовлетворить потребности любых пользователей. Чашки Петри изготавливаются в условиях «чистой комнаты» и дополнительно стерилизуются гамма-излучением. Воздух непрерывно очищается от пыли на всех этапах производства от изготовления до упаковки. Содержание пыли и бактерий в воздухе проверяется регулярно. Собственная лаборатория микробиологических испытаний и независимая лаборатория регулярно проводят тесты на наличие биологических загрязнений. По ходу всего производственного процесса также непрерывно проводится визуальный осмотр и проверка геометрии чашек Петри, например, гладкость. Оператор осматривает каждую стопку чашек Петри до упаковки её в полиэтиленовый чехол. В целях соблюдения стандартов гигиены и исключения малейшего риска загрязнения чашек Петри посторонними частицами, все коробки сначала укладываются во внешний полиэтиленовый пакет, а затем упаковываются в транспортную тару. Все эти меры гарантируют высокое качество чашек Петри.
Особенности круглых чашек Петри
- Совместимы с автоматикой.
- В наличии на складе в Москве.
- Стерильные и асептические.
- Вентилируемые и невентилируемые.
- Диаметр до 140 мм.
- Сертификат качества на каждую партию.
Применения
культивирование
культивирование
культивирование
Мы поможем вам подобрать и купить необходимое оборудование для лаборатории. Компания «МИЛЛАБ» работает с производителями напрямую, потому у нас объективные цены на всю продукцию и устройства!
Компания МИЛЛАБ предлагает услуги собственной сервисной службы, которая обеспечивает бесперебойную эксплуатацию оборудования, поставляемого нашей компанией, профессиональное сервисное обслуживание для максимального использования всех функциональных возможностей оборудования:
1. Выполнение пуско-наладочных работ лабораторного и технологического оборудования.
2. Обучение операционного персонала наших клиентов.
3. Гарантийное обслуживание в соответствии с требованиями предприятия-изготовителя.
4. Ремонт лабораторного оборудования.
5. Ремонт испытательного и технологического оборудования, в том числе заправка хладагентами термостатов, климатических камер и морозильных шкафов.
6. Техническое/регламентное обслуживание поставляемого оборудования.
7. Валидация оборудования для фармацевтических производителей.
8. Поставка оригинальных запчастей.
Мы работаем с юридическими и физическими лицами по безналичному расчету.
После уточнения всех необходимых деталей, менеджер вышлет вам счет на оплату по электронной почте.
Счет оплачивается через банк.
Для физических лиц предоставляется кассовый чек.
Доставка осуществляется по России и странам СНГ транспортными компаниями Деловые Линии и Желдорэкспедиция.
Если вы предпочитаете работать с другой транспортной компанией, необходимо указать в заявке название компании, сайт.
Точная стоимость доставки рассчитывается менеджером при подтверждении заказа в зависимости от характеристик оборудования и населенного пункта места назначения.
Вы можете забрать оборудование сами с нашего склада, который расположен по адресу г. Мытищи, Московская обл, ул. Силикатная , д. 19, стр. 16.
Для самовывоза необходимо предварительно согласовать с оператором склада дату и время получения товара.
Для получения товара необходимо предоставление доверенности организации, а для получения товара при оплате физическим лицом необходим паспорт.
Вы можете не печатать документ полностью, а выбрать страницы с описанием интересующих вас моделей в параметрах печати